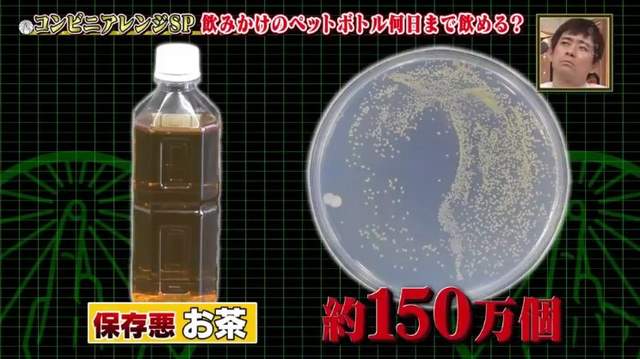
圖片12

便利商店的習慣《瓶裝茶飲打開可以放幾天》中居正廣放5天繼續喝被說超噁心……

圖片來自:電視截圖
走進便利商店一定會看到放滿整個冰箱的瓶裝茶飲,這些寶特瓶飲料雖然一次喝不完可以蓋起來之後再喝,但是裡面的細菌卻已經開始大量滋生了!多位日本藝人最近在綜藝節目上聊起瓶裝茶飲打開以後最長會放幾天,主持人中居正廣竟然可以忍受放了5天繼續喝,被其他人吐槽太噁心!大家又可以接受瓶裝茶飲打開放幾天呢……
原汁原味的內容在這裡綜藝節目聊起便利商店的美食

圖片來自:電視截圖

圖片來自:電視截圖

圖片來自:電視截圖
由中居正廣(中居正広)主持的日本綜藝節目「なかい君の学スイッチ」聊起便利商店的美食,當主題轉移到茶飲的時候提出了一個問題……
「喝過的瓶裝茶飲可以接受過了幾天繼續喝?」

圖片來自:電視截圖
便利商店的瓶裝茶飲在密封當時都有經過殺菌程序,一旦打開接觸外界的空氣甚至大家的嘴巴都會讓細菌快速滋生,因此棚內來賓們都不敢放太久……
「如果放冰箱可以3天」

圖片來自:電視截圖
「我就算放冰箱也不想超過1天」

圖片來自:電視截圖
而主持人中居正廣竟然覺得來賓們太小題大作,反正都是「自己的細菌」有什麼好怕!
「反正都是自己的細菌吧?」

圖片來自:電視截圖
「我冬天放在車裡可以接受放了5天繼續喝」

圖片來自:電視截圖
這番言論讓來賓們傻眼直呼噁心,還被八卦雜誌轉述報導,討論區的日本網友大部分都只能接受放個2、3天……
「超過100萬個細菌就有食物中毒的可能」

圖片來自:電視截圖
節目請專家測試各種瓶裝茶飲開瓶放一天之後的生菌數目,發現礦泉水有60萬個細菌,運動飲料1600萬個,咖啡歐蕾高達2億個最誇張!至於茶類則是……
藉著「兒茶素」抑制只有10萬個!

圖片來自:電視截圖
但是保存環境如果很差也可能高達150萬個!
圖片來自:電視截圖
即使專家都警告瓶裝飲料打開不要放太久了,中居正廣還是當耳邊風,讓來賓們都露出難以置信的表情……
「我還挺健康的呢!」

圖片來自:電視截圖

圖片來自:電視截圖

圖片來自:電視截圖
「這8年多都沒得過感冒咧!」

圖片來自:電視截圖
(゚д゚)大家又可以接受飲料開罐放多久繼續喝呢?
( ´_ゝ`)台灣的天氣在車裡放一天就超級噁心了吧……
部分資料來自網路 ( 日刊大衆5ちゃんねる )

0 則回應
順序: 新│舊












































